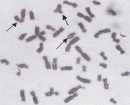

|
|
|
|
|
|
|
|
|
|
|
|
|
|
|
|
|
EK hücre kolonileri giemsa ile boyandığında farklılaşmamış koloniler koyu boyanırken, farklılaşan
koloniler daha açık tonlarda boyandılar.
Farklılaşmamış kolonilerin sınırları, çizgiyle çizilmiş
gibi belirgin ve net olduğu halde, farklılaşmaya
başlayan kolonilerin sınırları dağılan hücrelerden
dolayı belli belirsiz bir görünüme sahipti.
hedeflemekte. Besiyerine uygulanan büyüme faktörü kombinasyonlarının, miktarlarının ve zamanlamasının hesaplanması, hücrelerarası maddenin yerini alabilecek polimerik malzemeler ve üç boyutta doku gelişimini destekleyecek biyomateryal-ler ve matematiksel modellerin geliştirilmesi bu alanın sorumluluğunda. Amaç, tümüyle yapay bir ortamda hücrelere istenileni yaptırabilmek.
TÜBİTAK CMBAE Transgen ve Deney Hayvanları Laboratuavrında 2004 yılında bir kök hücre biyomühendisliği çalışması gerçekleştirildi. Kültür ortamındaki hayvansal ürünler olabildiğince uzaklaştırılarak, besleyici tabakaların yerini alabilecek, olabildiğince sentetik bir kültür sistemi geliştirilmeye çalışıldı. Besleyici tabakalar yerine Üç boyutlu fibröz bîr matris; serum yerine 'serum replacement' denilen sentetik bir çözelti kullanıldı.
Öncelikle hücreler besleyici tabakaların üzerinde altı farklı besiyerinde kültüre edildi. Popu-lasyon katlanma sayıları ve farklılaşmamış kolonilerin oranına göre en iyi besiyeri tanımlandı. Kullanılan çözeltilerin hücrelerin çoğalmaları üzerine bir etkisi olmadığı, ancak Serum Replacement (SR) uygulanan deney gruplarında kolonilerin daha az oranda farklılaşmış fenotip gösterdiği tespit edildi. Böylelikle deneyin ilk aşamasında hücrelere uygun bir kimyasal çevre hazırlanmış oldu.
Deneyin ikinci aşamasında hücrelerin kültüre olduğu fiziksel çevre değiştirildi. Besleyici tabakaların üzerinden alınan EK hücreleri üç boyutlu fibröz bir matris olan dokunmamış poliester fabrik-lerinin (NWPF) üzerine aktarıldılar. NWPF diskle-
|
|
|
|
|
|
|
|
Embriyonik kök (EK) hücreler hasar görmüş dokuların yenilenmesi için eşsiz birer hücre kaynağıdır. Klinikte hasarlı dokuların yenilenmesi için aynı düzeyde farklılaşmış çok sayıda hücreye gereksinim duyulur. Teorik olarak EK hücreler sınırsızca bölünebildikleri için İstenilen sayıda hücreyi; vücuttaki hemen her çeşit hücreye dönüşebildikleri için de ihtiyaç duyulan tipte farklılaşmış hücre tiplerini oluşturabilirler. Ancak uygulamada durum farklıdır. Bu hücrelerin, kendileri gibi kök hücreler oluşturarak çoğalmalarını yani 'yenilen-me'lerini sağlamak zordur; çünkü EK hücre doğası gereği başka hücrelere farklılaşmak ister. Farklılaşmanın önüne geçebilmek için EK hücreler fare embriyolarından yalıtılan fibroblastlar üzerinde kültür ortamına sokulurlar, Fare embriyonik fib-roblastları, saldıkları birtakım faktörlerle EK hücreleri desteklerler. EK hücrelerin altında, kültür kaplarının yüzeyini tamamen kaplamış bu tek tabakalı hücre grubuna besleyici tabaka da denir.
|
Hücrelerin daha sağlıklı ve farklılaşmadan çoğalmalarını sağlasa da hastalık tedavisinde kullanılacak insan EK hücrelerinin, hayvan hücrelerinin üzerinde kültüre edilmesi riskli. Fare hücrele-rindeki retroviruslar EK hücrelerin genomlarında mutasyonlara yol açabilirler. Bunun önüne geçmek için değişik tipte insan hücreleri besleyici tabaka olarak denenmiş durumda. Örneğin, 2003 yılında İsrail'de yapılan bir çalışmada, insan EK hücreleri yeni doğan bebeklerin sünnet edilmiş dokularından elde edilen hücrelerin üzerinde uzun dönem kültüre edilebilmiş.
Hücre kültüründe EK hücreleri kontrol etmenin yolu, tanımlanmış bir mikroçevreden geçiyor. Besiyeri bileşenleri, kültür kabı yüzeyleri, hücrelerin birbirleriyle komşulukları, bir hücrenin mikro-çevresini belirleyen koşulları oluşturuyor. Son yıllarda hızla gelişen bir dal olan kök hücre biyomü-hendisliği, kök hücrelerin istenilen yönde farklıla-şıp çoğalmaları için mikroçevreler yapılandırmayı
|
|
|
|
|
|
|
|
|
|
|
|
|
|
|
|
EK hücre kolonilerinin faz-kontrast mikroskoptaki görüntüleri. Farklılaşmamış hücrelerin birbirleriyle etkileşimi daha kuvvetlidir. Bu hücrelerin meydana getirdiği kolonilerin sınırları, çizgiyle çizilmişçesine belirgin olur ve faz kontrast filtrede parlak gözükürler. Yapılan çalışmada besleyici tabakaların üzerinde kültüre edilen koloniler besiyeri birleşenlerine göre farklı morfolojiler gösterdiler. SR içeren besiyerlerindeki koloniler daha belirgin sınırlara sahip, daha yuvarlak ve pürüzlü yüzeyler gösterirken, serumla kültüre edilen besiyerlerindeki koloniler daha basık ve pürüzsüz bir görünüme sahipti.
|
|
|
|
|
|
|
|
BİLİMveTEKNİK 58 Ağustos 2005
|
|
|
|
|
|
|
|
|
|
|
|
|
|
|
|
|
|
|
|
|
|
|
|
|
|
|
|
|
|
|
|
|
EK hücre kolonilerinin alkalin fosfata* aktiviteleri ( x 200). Farklılaşmamış EK hücreleri daha yüksek alkalin iosfataz aktivitesi göstererek daha koyu tonlarda boyandı-lar. Farklılaşan ve koloni yapılarını kaybedenler ise daha açık tonlarda boyanarak daha düşük alkalin fosfataz etkinliği gösterdiler.
|
|
|
|
|
|
|
|
ri Hacettepe Üniversitesi Biyomühendislİk Bö'lü-mü'nden Prof. Dr. Menemşe Gümüşderelioğlu ve ekibi tarafından hazırlandı. Bu matrisin malzemesi ameliyat İpliklerinde ve damar greftlerİnde de kullanılan bir biyomateryaldi. En büyük avantajı geniş yüzey ve alan hacmine sahip olmasıydı. Böylelikle besleyici tabakalarla sadece petri yüzey alanında kültüre olan hücreler, NWPF diskleri kullanıldığında aynı büyüklükteki petrinin içinde çok daha geniş bir alanda kültüre oldular.
|
Fare EK hücreleri LİF (Lösemi Önleyici Faktör) kullanıldığında farklılaşmadan çoğalırlar. LİF insan EK hücreleri üzerinde bir etki göstermezken, bazı fare EK hücre hatlarında besleyici tabakanın yerini alabilecek kadar güçlü bir etkiye sahiptir. Bu çalışmada model olarak fare EK hücre hattı Rİ kullanıldı. Kullanılan matrislerin yüzeyine LİF sabit-lendi. Böylelikle hücrelerin daha geniş alanda daha fazla farklılaşmayı önleyici faktörle daha uzun süre kültüre edilmesi sağlandı. UF'in yüzeye sabit-
|
lenmiş formu hücrelerle daha uzun süre etkileşe-ceği için etkinliğinin artacağı düşünüldü.
İlk denemeler çok heyecanlıydı. Hücrelerin böyle fibröz bir yapıda nasıl kolonize olacaklarını merak ediyorduk. İlk 48 saat içinde hücreleri fiberler (lifler) arasında gözlemek kolay olmadı. İlerleyen günlerde matris üzerinde fiberlerin arasını kaplamış çok büyük hücre agregatları (toplulukları) gözlendi. Bu agregatları gözlemleyebilmek için kültürasyon en geç 4. günün sonunda durduruldu. Hücrelerin farklılaşmaya mı başladıklarım yoksa kendilerini mi yeniledikleri merak ediliyordu. Önce giemsa boyasıyla koloni morfolojilerini incelendi, sonra SSEA-l'e karşı bağışıklık tepkisi ve alkalin fosfataz aktivitesine bakıldı. Son olarak da kolonilerin elektron mikroskobu görüntülerini alındı. Bazı koloniler tripsinle matristen ayrıldı, besleyici hücre tabakalarının üzerine ekildi ve hücrelerin eski ortamlarında nasıl davrandıkları izlendi. Polimerik matris deneyleri iki koldan yürütüldü'. UF sabitlenmiş yüzeylere sahip NWPF disklerle, hidrolize edilmiş yüzeylere sahip NWPF diskleri üzerinde EK hücrelerin gelişimi ayrı ayrı izlendi.
Sonuçlar, LIF sabitlenmiş yüzeylerde EK hücrelerin daha az farklılaştığını gösterdi. Hidrolize yüzeylerde kültüre edilen hücrelerin besiyerine LİF eklenmesi, farklılaşmaların önüne geçemedi. Çalışmanın en umut verici yanı fiber yüzeyindeki, immobilize (hareketsiz) formdaki LIF'in çalışma-siydi. Bu, kök hücre biyomühendisliği çalışmaları için yeni bir fikirdi. Bu çok pahalı faktörü besiyerine sürekli dışarıdan eklemek yerine, matris yüzeyine sabitlemenin EK hücre yenilenmesi için hem etkili hem de ekonomik bir yol olabileceği gösterilmiş oldu.
Bu çalışma, ülkemizde embriyonik kök hücrelerin farklı kültür koşullarında ve polimerik yapılar üzerinde kültürü ile yapılan ilk çalışma olduğu için önemliydi. Elde edilen sonuçlar, embriyonik kök hücrelerin farklılaştırmadan kültüre edilebilmeleri için, daha iyi tanımlanmış ortamların geliştirilebilmesine yönelik bundan sonraki çalışmalara ışık tutacak.
Gaye Çetinkaya
Doç. Dr. Sezen Arat
TUBITAK-GMBAE Transgen ve
Deney Hayvanları Laboratuvarı
|
|
|
|
|
|
|
|
EK hücre kolonisinin PET fiberleri arasındaki görüntüsü (x 400).
|
EK hücreler fiberler arasında büyük hücre agregatları ( x40). Büyük hücre toplulukları, LİF sabitlenmiş yüzeylerde yüksek alkalin fosfataz etkinliği gösterdiler.
|
|
|
|
|
|
|
|
Giemsa ile boyanmış EK hücre kolonilerinin PET fiberleri arasındaki görüntüsü ( x 200).
|
PET fiberler arasındaki EK hücre kolonisinin SSEA-l'e karşı bağışıklık tepkisi (x 200).
|
|
|
|
|
|
|
|
Giemsa ile boyanmış EK hücre kolonisinin PET fiberleri arasındaki görüntüsü ( x 400).
|
EK hücre kolonisinin LİF sabitlenmiş yüzeylerdeki elektron mikroskobik görüntüsü.
|
|
|
|
|
|
|
|
|
|
|
|
|
|
|
|
|
|
|
|
|
|
|
|
|
|
|
|
|
|
|
|
|
|
|
|
|
|
|
|
|
|
|
|
|
Kimyasal maddelerin yoğun ve kontrolsüz olarak kullanılmaya başlandığı yıllarda yapılan
hatalardan insan sağlığı ve çevre büyük zarar gördü. Gerek kimyasal maddelerin her
alanda yoğun olarak kullanılmaya başlanması, gerekse kontrolsüz kullanımın yarattığı ciddi
sağlık ve çevre sorunları, toplumlarda kimyasal kullanımına karşı oluşan korku ve tepkinin
nedeni. Kimyasalların insan sağlığı üzerindeki etkileri de devamlı tartışma konusu olmakta.
Ankara muhabirimiz Gökçe Taner de, Prof. Dr. Fatma Ünal danışmanlığında kimyasal
maddelerin canlılar üzerindeki etkilerini ve kromozomlarımız üzerine toksik etkide bulunan
maddelerle ilgili araştırmalarda bulunan genotoksikoloji bilim dalının çalışmalarını anlatıyor.
GENOTOKSİKOLOJI
|
|
|
|
|
|
|
|
|
Çağımızın en önemli sorunlarından biri hiç kuşkusuz, tüm canlıları, özellikle de insanı olumsuz yönde etkileyen çevresel tehlikelerin her geçen gün artması. Bu tehlikeler içinde belki de en önemlisi, modern yaşamımızın vazgeçilmezi, iç içe yaşadığımız kimyasal maddeler. Bundan dolayı; çevreyi kirleten, doğal dengeyi bozarak yeni sorunların ortaya çıkmasına neden olan,canlıları değişik şekillerde ve değişik oranlarda zehirleyen kimyasal maddelerin canlılar üzerindeki etkileri sorunu günümüz araştırıcılarının son derece İlgisini çekmekte. Yapılan araştırmalar doğal çevremize bulaştırdığımız pek çok kimyasal maddenin kanserojenik ya da mutajenik etkiye sahip oldukları gerçeğini ortaya koyuyor. Kanserojen (ya da karsinojen) kansere neden olan, mutajen mutasyona yani kalıtsal materyalde (DNA) herhangi bir değişikliğe neden olan anlamına geliyor. Genler üzerinde toksik etkisi olan kimyasal maddelereyse genotoksik deniliyor.
Türk Toksikoloji Derneği'nin bilgilerine göre; günümüzde 80.000 civarında kimyasal madde çeşitli amaçlar için kullanılmakta ve bu sayı her geçen yıl artmakta. Kimyasallar, ilaç aktif maddeleri (4 000), ilaç yardımcı maddeleri (2 000), kozmetikler (3 000), gıda katkı maddeleri (2 600), tarım ilaçları (1 500) ve endüstriyel kimyasallar (48 000) olarak dağılım göstermekte. Ayrıca kullanılan kimyasallara da her yıl 1 000 yeni kimyasalın eklendiği hesaplanmakta. 20. yüzyılın başında çoğu doğal kaynaklı olan kimyasalların sayısı birkaç bin ile sınırlıyken, özellikle 1940'lardan sonra bu sayı hızla arttı. Sayısal olarak artışın yanı sıra miktar olarak da hızlı bir artış söz konusu. Birleşmiş Milletler Çevre Progra-mı'nın (UNEP) verilerine göre, 1950'de 7 milyon ton/yıl olan dünya kimyasal madde üretimi, 1970'te 63 milyon ton/yıl'a ve 1985'te 250 milyon ton/yıl'a yükseldi. Şimdilerde bu rakamın 400 milyon ton/yıl'a ulaştığı tahmin ediliyor. Yani biz istesek de istemesek de kimyasal maddeler yaşantımızda doğrudan ya da dolaylı olarak çok önemli bir yer tutmakta.
1960'lardan sonra toksikoloji bilimindeki hızlı gelişmeler ve kimyasal maddeler İçin risk yönetimi uygulamalarının geliştirilmesiyle birlikte güvenli kimyasal kullanımının önemi gündeme geldi. Bugün ilaç, gıda katkı maddesi, kozmetik, tarım ilacı, endüstri kimyasalı olarak kullanılan her türlü kimyasalın insan sağlığı ve çevreye olan etkisi ayrıntılı olarak incelenmekte, insan sağlığı ve çevre üzerinde kabul edilemez ölçüde risk taşıyanların kullanımına izin verilmemekte. Her faaliyet değişen oranlarda risk taşır. Risk bir olaydaki istenmeyen sonuçların gerçekleşme olasılığıdır. Modern yaşamın vazgeçil-
|
|
yapılmakta. Bu çalışmalar zahmetli olmakla birlikte kimyasallar hakkında güvenilir sonuçlar elde edilmesini sağlamakta. Genotoksisite çalışmalarında, etkisi araştırılan kimyasal için çok sayıda kromozom preparatlarının hazırlanması, anormallik oranlarının ayrı doz ve süreler için belirlenmesi, bu aşamada yüzlerce hücrenin mikroskopta sayılması, incelenmesi ve İstatistiksel hesaplamalarla sonuca gidilmesi gerekmekte.
Kromozomlar; hücrelerin çekirdeğinde bulunan, DNA ve proteinden oluşmuş, sayısı ve şekli her canlı için sabit olan, hücre bölünmesi sırasında iplikler halinde ortaya çıkan ve koyu renkli boyanan yapılar. Kromozomlar üzerinde genler dizili. Her kromozom çok uzun bîr DNA molekülü ve bu molekülle birlikte bulunan proteinlerin çok sayıda sarmallar meydana getirmesiyle, hücre bölünmesinin metafaz safhasında gözlenebilir duruma gelir. İnterfazda sarmalların kısmen ya da tamamen çözünmesi nedeniyle kromozomlar ayırt edilemezler. İnsan ya da diğer canlıların kromozomlarını inceleyebilmek için aranan ilk koşul, hücrelerin bölünme döneminde olmasıdır. Bu özellikteki hücreler, yani bölünme durumundaki hücreler çeşitli yöntemlerle elde edilir. Çalışmalarda, herhangi bir dış uyarana gerek kalmaksızın vücutta sürekli bölünmekte olan hücreler (örneğin kemik iliği hücreleri) kullanılabilir. Diğer bir yöntemdeyse vücuttan alınan hücreler (örneğin lenfositler) yapay uyarıcılarla mitoz bölünmeye sokularak kullanılabilir. Kromozom çalışmaları için, bölünmenin çok olduğu soğan ya da başka bitkilerin kök ucu hücreleri gibi materyaller de kullanılmaktadır.
Çeşitli dokularda kromozomlar, mitoz bölünmenin metafazında en iyi şekilde görülebilirler. Çünkü bilindiği gibi kromozomlar mitozun metafaz evresin-deyken en fazla kısalmış ve kalınlaşmış haldedirler. Kromozom incelemesinin yapılabilmesi İçin, çok sayıda metafaz hücresi bulunmalıdır. Oysa bu çalışmalar için en çok kullanılan materyallerden biri olan insan periferal kan lenfositleri normal olarak %1 gibi düşük bir oranda kendiliğinden bölünmeye girerler. Bu yüzden fitohemaglütinin (PHA) denilen maddeyle hücre kültürlerinde üretilen lenfositler yapay olarak mitoza sokulurlar. Ancak işlem bununla bitmez. Mitoz bölünmenin metafaz evresine girmiş olan hücre, belli bir süre sonra, anafaz evresine geçecektir ve bu çalışmalarda istenen, hücrenin metafaz evresidir. Bu amaçla, yani mitoz bölünme durumundaki hücrelerin metafazda birikmeleri için, hücrelerin iğ ipliklerinin parçalanmasını sağlayan kolşisin (colchi-cine) denilen madde kullanılır.
Mitoz bölünme sırasında kromozomlar sayılarının çokluğu ve hücrelerin küçüklüğü nedeniyle ol-
|
|
|
|
|
|
|
|
|
|
|
|
Kromatid değişimi, kardeş D kromatidlerde birleşme, kromatid kırığı
|
|
|
|
C Kromozom kırığı
İnsan perfîeral lenfositlerinde meydana gelmiş olan
kromozom anormallikleri örnekleri mez unsurları olan kimyasal maddelerin kullanımında da insan sağlığı ve çevre için riskler her zaman söz konusu.
Sözcük anlamı zehir bilimi olan toksikoloji, kimyasallarla biyolojik sistem arasındaki etkileşimleri zararlı sonuçları yönünden incelemekte. Toksikoloji kimyasalların zararsızlık limitlerini inceleyen bilim dalı ve inceleme alanlarına göre çeşitli alt dallara ayrılmakta. Toksikolojinİn bir alt dalı olan ve kimyasalların, çeşitli hücre genetiği teknikleriyle elde edilen kromozomlar üzerine etkilerini inceleyen bilim dalı "genotoksikoloji" olarak adlandırılmakta. Kromozom tekniklerinin gelişmesinden sonra kimyasalların genotoksik etkileri de incelenmeye başlandı.
Günümüzde genetik laboratuvarlarında pek çok kimyasalın genotoksik etkileri üzerine çalışılmalar
|
|
|
|
|
|
|
|
Bilim ve Teknik Kulübü hakkında ler türlü bilgiyi, mektup, telefon, faks ya da e-posta aracılığıyla edinebilirsiniz. İletişim kurabileceğini; adreslerse şöyle: Bilim ve Teknik Kulübü, Atatürk Bulvarı No:221 Kavaklıdere- Ankara,
|
|
|
|
|
|
|
|
BİLİM ve TEKNİK 28 Eylül 2004
|
|
|
|
|
|
|
|
|
|
|
|
|
|